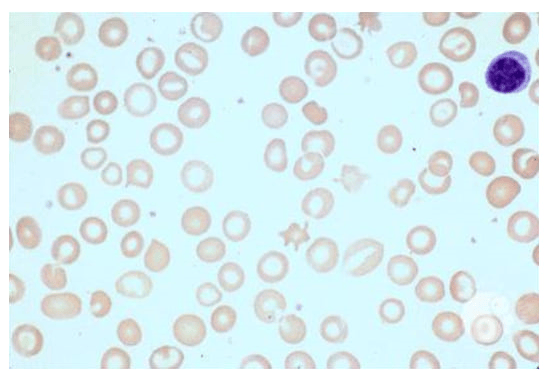

Anemia
A 15-year-old female with significant past medical history presents to the Emergency Department with lightheadedness and a fainting episode at school.
She fell at school when getting up to stand between classes. She was caught by her friend and did not hit her head. Prior to her fall, the patient was in her usual state of health with normal activity. She does not take any daily medications. This is the first time she has passed out, but reports feeling dizzy sometimes when she stands up. She also reports ongoing fatigue for the past year. She has not had any headaches, chest pain, weight loss, or change in activity. No recent fevers or illnesses. She had her first period when she was 13 years old. Her last menstrual period was 1 week ago. Describes her periods as heavy, often bleeds through 5 pads per day for 5 days. Her older sister used to take vitamin supplements for heavy periods but no longer does. There is otherwise no family history of cardiac problems, bleeding disorders, or malignancy.

Pallor/Anemia | The Atlas of Emergency Medicine, 5e | AccessMedicine | McGraw Hill Medical
2+ Thousand Pallor Royalty-Free Images, Stock Photos & Pictures | Shutterstock
Pallor and its Grading | PSM Made Easy
Cartoon Anemia Vector Images (over 380)
The image highlights classic exam findings of anemia: pale conjunctiva, pale palms and nail beds, and a generally tired or dizzy appearance. A text box lists reassuring negatives, including normal heart, lung, abdominal, neurologic exams and no bruising or organomegaly. The visual emphasizes that despite a normal systemic exam, subtle pallor and systemic symptoms point toward anemia.
The image uses seven buckets to organize possible causes of symptoms such as fatigue or dizziness. Categories include neurologic and psychological conditions (like seizures or anxiety), endocrine disorders, hematologic causes such as iron deficiency or acute bleeding, nutritional and toxicologic issues including vitamin deficiency and lead poisoning, oncology-related causes, and cardiac etiologies like arrhythmias or vasovagal syncope. The buckets provide a structured way to think through broad diagnostic possibilities across multiple systems.
Initial Evaluation
- Obtain a CBC with differential to check white cell and hemoglobin levels
- Obtain blood smear to better characterize white/red cells
- Obtain reticulocyte count to see if the body is responding appropriately if hemoglobin is low
- Obtain iron studies to look for iron deficiency
- Obtain EKG, thyroid studies, Vitamin D level, and Vitamin B12 level
- Obtain a diet history and SSHADESS assessment (strengths, school, home, activities, drugs, emotions/eating, sexuality, safety)
Lab Results
- CBC showed a low hemoglobin to 8 (normal is 12-15) with a decreased MCV (Mean Corpuscular Volume) and increased RDW (Red Cell Distribution Width). Otherwise normal.
- Low reticulocyte count
- Iron studies showed low serum iron, low ferritin, low transferrin saturation, and high TIBC (total iron binding capacity)
- EKG, thyroid studies, and vitamin levels were all normal
- Blood smear showed pale red cells (hypochromia) in a range of sizes (anisocytosis). See picture below
- On SSHADESS assessment, she describes being a picky eater. Otherwise her mood is good, she feels safe at home, and does not endorse anxiety or depressive symptoms.
Diagnosis: Iron Deficiency Anemia!
How we got there: This patient’s labs showed a significant anemia with evidence of iron deficiency (low MCV, high RDW, and hypochromic cells on smear). Iron deficiency in this patient is secondary to blood loss from heavy menstrual periods, as well as iron poor diet. We are reassured against other diagnoses we considered given her otherwise normal workup, lack of family history of thalassemia, and normal SSHADESS exam.
Management
- Blood transfusion for severe (Hgb <7) or symptomatic (lightheaded, dizziness, fatigue) anemia
- Treat with ferrous sulfate (65-140 mg elemental iron) daily for at least 3 months
- Recheck CBC 4 weeks after initiation of iron therapy and CBC + ferritin in 3 months and 6-12 months after stopping iron supplementation
- In severe cases or when unable to tolerate oral therapy, iron can be given as an IV infusion.
- Address the underlying etiology of excessive menstrual blood loss, and give dietary counseling (increase consumption of red meats, iron fortified grains, and/or leafy green vegetables)
- Anemia is defined as hemoglobin concentration > 2 standard deviations below the mean for same healthy population sex and age
- Anemia is broadly split into three categories based on the size of the red blood cells: microcytic (smaller than normal), normocytic (normal size), and macrocytic (larger than normal). You can further target your workup based on what you see on initial CBC.

Image Source: Anemia: Overview and Types | Concise Medical Knowledge
The chart organizes anemia by MCV into microcytic, normocytic, and macrocytic groups, listing key causes for each. Normocytic anemia is further divided by corrected reticulocyte count: low counts suggest decreased production, while high counts indicate intrinsic or extrinsic red blood cell defects. The diagram provides a stepwise approach to identifying underlying etiologies such as iron deficiency, hemoglobinopathies, hemolysis, nutrient deficiencies, and chronic disease.
- Iron deficiency causes a microcytic anemia, and is the leading cause of anemia for children and adolescents, and risk increases 10x for females after menarche. Other risk factors are vegetarian or vegan diet, low body weight or malnutrition, history of underlying bleeding disorder, presence of chronic illness
- Many patients with iron deficiency are asymptomatic or symptoms can be nonspecific including weakness, headache, irritability, fatigue, or exercise intolerance.
- Different patterns of hemoglobin, MCV, iron studies, and smear findings can help differentiate between different types of microcytic anemia

- *Image Source
-
The table contrasts how iron deficiency anemia, alpha or beta thalassemia, and anemia of chronic disease present on routine labs. It highlights differences in hemoglobin, MCV, RDW, RBC count, smear morphology, and iron studies such as serum iron, TIBC, transferrin saturation, and ferritin. These patterns help distinguish between the three conditions when evaluating microcytic or normocytic anemia.
-
All children and adolescents should be screened based on history at routine health care maintenance visits with laboratory screening for those with risk factors
Click the drop down to reveal the correct answers
Q1: What are the common laboratory findings of Iron Deficiency Anemia?
- High ferritin, low serum iron, low total iron binding capacity, low transferrin saturation
- Low ferritin, low serum iron, high total iron binding capacity, low transferrin saturation
- Low ferritin, low serum iron, low total iron binding capacity, high transferrin saturation
- High ferritin, low serum iron, high total iron binding capacity, high transferrin
Q2: What sign/symptom is concerning for further work up in patient with iron deficiency anemia?
- Fatigue
- Dizziness
- Blood in the stool
- Pica
Answers:
Q1: B
Q2: C
- Podcast
- Primary Care Perspectives: Iron-deficiency anemia
- Article
- American Family Physician: Evaluation of Anemia in Children
- Iron Deficiency Anemia in Infancy, Childhood, and Adolescence
- Video